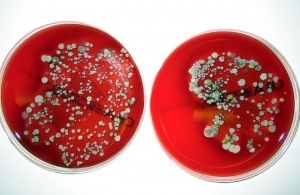

Google tracks more than just your cellphone usage,it can track the spread of MRSA, and it’s actually very interesting as to how it’s done. Check out the image to the right, that has a representation of Google Searches and the infected MRSA people in hospitals, if you look at the trend in Red, you can see that as the trend goes up and down, the searches for Google also go up and down. This is because the people infected by the MRSA – methicillin resistant staphylococcus aureus, always resort to online searches to figure out how to cure something… How many times have you found a small wound in your body and instantly go to WebMD to figure out that even a small mosquito bite comes back as cancer?
Currently there is no Surveillance mechanism for the tracking of MRSA so this is actually very cool to have, hospitals and scientist have no way of figuring out how the infection rate of MRSA is changing over time, but thanks to Google we can now see the trend. I wouldn’t recommend basing anything like this on Google searches alone primarily because if you look in between 2007 and 2008 there was a huge spike, if I was a doctor and saw that spike I’d be like “holly crap! it’s an epidemic” when in reality it was just 5 thousand people trying to figure out why they have a minor bump on their skin on WebMD and it came back as “you have MRSA”
This Google Search timeline is similar to that used by Google Flu Trends, when it caught researchers’ attention after flu symptom-related searches in Mexico preceded the 2009 swine flu outbreak.
But whereas Flu Trends was seen as a potential source of early warning signs, better methods of MRSA surveillance are necessary to understand what’s already happening.
“If we had a comprehensive, linked electronic health records system that researchers had access to, we wouldn’t need it. There are systems like that in Scandinavian countries, where you can analyze disease factors in all kinds of ways. But you can’t do that in the U.S,” said Lauderdale.
Added study co-author Michael David, a University of Chicago MRSA specialist, “Right now, in the U.S., there is no surveillance system to track MRSA infections overall.”
Another reason that the Google trend is difficult to be reliable is the fact that many people searching for MRSA actually search for Mersa which is the phonetically correct way of pronouncing MRSA. Also, the trend is thrown off balance due to media out breaks or popular articles. Regardless of what they are searching, if you are a good researcher you can see trends in many different things using Google Alone, you just have to decipher whats real and whats “popular”.
Via: Wired